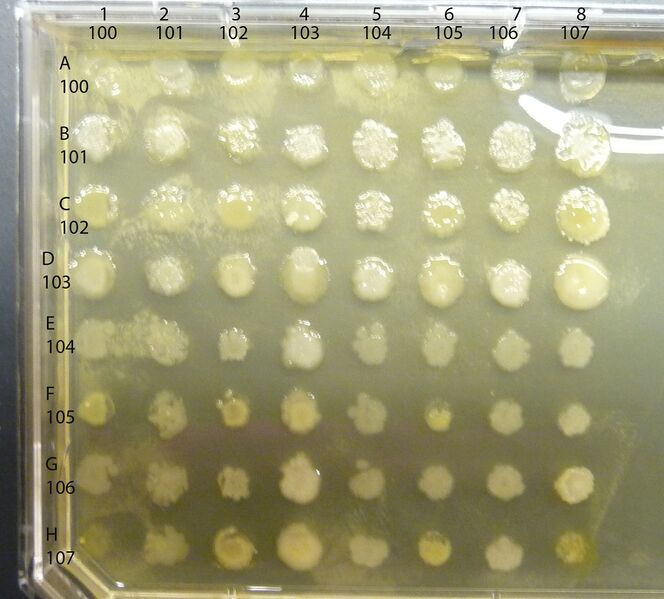
File:Interactions cropped.jpg

File:Interactions cropped.jpg
From OpenWetWare
Jump to navigationJump to search
Size of this preview: 664 × 599 pixels. Other resolution: 2,034 × 1,836 pixels.
Original file (2,034 × 1,836 pixels, file size: 2 MB, MIME type: image/jpeg)
File history
Click on a date/time to view the file as it appeared at that time.
| Date/Time | Thumbnail | Dimensions | User | Comment | |
|---|---|---|---|---|---|
| current | 19:39, 13 January 2012 |  | 2,034 × 1,836 (2 MB) | Tucker Crum (talk | contribs) |
You cannot overwrite this file.
File usage
There are no pages that use this file.